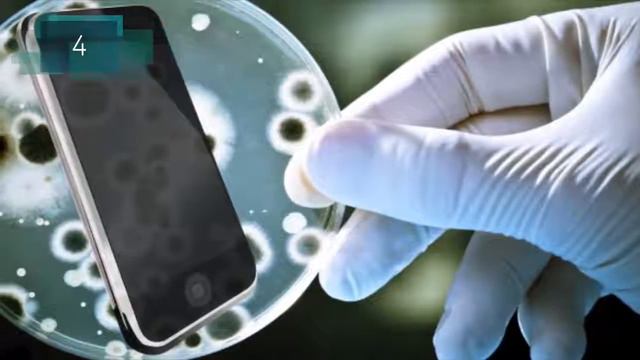
7 вещей с телефоном которые вы делаете неправильно смотреть онлайн

Автор / Канал: Романтические истории о любви и душевности Страница 12

ОТВЕТ ПСИХИАТРА ПО ВРЕДИНЕ. VREDINA LIFE.

Хорошая новость

в следующем видео буду писать в роблоксе а не говорить очень тихо

Песня Гренландия

Успешные люди встают рано! avi

После прогулки, занятия.#кокерляля #собакадругчеловека #животные

Говорят на твинах отдыхaют((LOL Wild Rift Stream !!! #stream #mlbb#moba#lol #wildrift#Injustice2

Рандомные покатушки 26.2.23.

Почему Ошибки это ХОРОШО?!

Crossout | Спектр тащит(Фоксу на память).

ВНУЧКА НЕ ХОЧЕТ КАКАТЬ В ВЕДРО (ГЛАД ВАЛАКАС)
7 вещей с телефоном которые вы делаете неправильно

PMV "Mint Lilu - Деньги горят"

ДИЗЗИ УГАРАЕТ НАД ВЕБКОЙ | АМЕРИКАНЕЦ И SNAP CAMERA

Новое достижение Поставщик года Родина Большой урожай

Хватит пичкать народ устаревшими знаниями! В новой эпохе старое не работает!

interlude Reborn X1 Lineage II 3rd Class Quest SpellHowler

13 RESONS WHY- VINE CLAY AND HANNA

India Flags Pakistan's 'Reds' At UN After They Bring Up Kashmir Issue

17.10.2021 "Почему Иисус говорил притчами"

Какой соус вкусней ? Вкусно и точка vs KFC vs Бургер Кинг

КАК трудно найти ПАРНЯ (аватария)

пой если ты 3 часть

Разжигание! Почему надо держаться подальше от онлайновых игр - zaddrot.com
За каждым успешным каналом стоит личность, идея и сотни часов кропотливого труда. Если вы здесь, значит, автор «Романтические истории о любви и душевности» уже сумел зацепить ваше внимание своим уникальным стилем или подачей. А мы на RUVIDEO позаботились о том, чтобы вы могли изучить весь архив его работ в максимально комфортных условиях — без лишней суеты и преград.
Почему за работами канала «Романтические истории о любви и душевности» так интересно наблюдать? Всё просто: это честный контент, который находит отклик в сердцах зрителей. На нашем ресурсе вы можете смотреть онлайн все видео любимого автора бесплатно и в хорошем качестве. Нам важно, чтобы вы видели каждую деталь и слышали каждый нюанс, поэтому мы используем только стабильные плееры из открытых источников Rutube.
Следите за новинками канала, пересматривайте старые шедевры и открывайте для себя новые грани творчества «Романтические истории о любви и душевности». Мы постоянно обновляем ленту, чтобы у вас под рукой всегда были самые свежие выпуски. Никаких сложных регистраций — только вы и творчество, которое вдохновляет. Приятного вам путешествия по миру авторского контента на RUVIDEO!
Видео взято из открытых источников Rutube. Если вы правообладатель, обратитесь к первоисточнику.